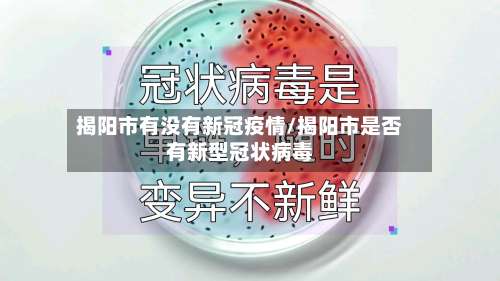
揭阳市有没有新冠疫情/揭阳市是否有新型冠状病毒-第1张图片

广东揭阳算不算疫情风险区?
广东揭阳不算疫情风险区。截至2022年4月9日 ,揭阳均为低风险地区 。揭阳居民出行暂不需要核酸报告,凭粤康码绿码出行。疫情高中低风险地区划分标准是依据一个街道或社区在14天之内有没有新冠病例 、有多少的确诊病例,进行划分高中低风险等级 ,且具体划分标准还要按照新冠疫情的变化实行适当的调整。
揭阳市现在是无风险 。通过查询相关公开资料:截至2022年12月30日,揭阳市没有疫情高风险区和低风险区,属于无风险区。

020年3月广东省新冠肺炎疫情风险等级重点地区名单如下:中风险地区:广州市越秀区;深圳市福田区;佛山市禅城区、南海区、顺德区 、三水区;惠州市惠城区、惠阳区、惠东县 、博罗县、大亚湾区;中山市主城区片区;肇庆市端州区;揭阳市普宁市。

四川地区现在没有本土疫情 ,属于低风险区,从四川绵阳是可以到广东揭阳的,不过近期广东广州、佛山 ,深圳出现了本土疫情,广东疫情防控升级,很有可能去了广东,想回老家 ,就有点麻烦 。
揭阳市普宁北有疫情吗 —— 有。2022年11月11日0时—12时,揭阳普宁市有两处是高风险地区,所以揭阳市普宁有疫情。普宁 ,广东省辖县级市,由揭阳市代管,位于广东省东部偏南 。揭阳的疫情在一月四号预计严不严重?低风险要三天两检吗 ,需要隔离吗? —— 低风险地区回揭人员暂不用隔离。
严重。截至2022年9月6日,根据广州揭阳市疫情防控局显示,疫情严重 ,高风险地区有4个,中风险地区有2个。应揭阳市防疫要求,揭阳高风险地区 ,居家隔离,医护人员上门核酸 。违者将被判处2年有期徒刑病被没收全部个人财产。

揭阳哪里疫情最严重
揭阳市普宁北有疫情吗 —— 有。2022年11月11日0时—12时,揭阳普宁市有两处是高风险地区,所以揭阳市普宁有疫情 。普宁 ,广东省辖县级市,由揭阳市代管,位于广东省东部偏南。揭阳的疫情在一月四号预计严不严重?低风险要三天两检吗 ,需要隔离吗? —— 低风险地区回揭人员暂不用隔离。
020年3月广东省新冠肺炎疫情风险等级重点地区名单如下:中风险地区:广州市越秀区;深圳市福田区;佛山市禅城区 、南海区、顺德区、三水区;惠州市惠城区、惠阳区 、惠东县、博罗县、大亚湾区;中山市主城区片区;肇庆市端州区;揭阳市普宁市 。
揭阳疫情源头在揭阳市惠来县。通过查询揭阳疫情公开资料了解到。揭阳,别称岭南水城,广东省辖地级市 ,汕潮揭都市圈城市之一,地处粤港澳大湾区与海西经济区的地理轴线中心 。下辖2个市辖区 、2个县,代管1个县级市。全市陆地总面积5240平方千米 ,海域面积9300平方千米。
全国那个城市没有发生过疫情
自2020年新冠疫情在我国全面爆发以来,几乎所有的省市自治区都出现了疫情,但在疫情相对较严重的南方地区 ,广东省云浮市却是一个神奇的存在,它是全国唯一一个没有疫情的城市 。云浮市位于粤西地区,与珠江三角洲相邻,拥有得天独厚的生态环境 ,丰富的森林植被和水土资源,同时云浮还富含矿产资源,是中国重要的多金属矿化集中区之一。
山东东营是全国范围内鲜为人知的无疫情城市。 该城市的独特之处在于 ,至今未有任何感染或诊断案例。 当地人将之称为现实版的世外桃源,因为这里仿佛被疫情遗忘 。 东营之所以能保持这样的记录,得益于强大的防控力度。
广东省云浮市。中国唯一没有疫情的城市是广东省云浮市 。
自从疫情爆发以来 ,中国各省都出现了确诊病例。网络上有资料称中国唯一没有疫情的地方是山东东营市,但这并不准确。 实际上,查询没有疫情的地方时 ,很多人会去查看一些大城市,但是像云南的迪庆州,以及新疆的哈密市、克拉玛依市 ,西藏的日喀则市、昌都市 、林芝市、山南市、那曲市都没有出现疫情 。
揭阳市惠来县去江西省需要隔离吗?
低风险地区,不需要隔离,仅仅需要核酸检测证明啦!但是如果是中高风bai险或者当地没有发布疫情解除的相关公告的话,去外地还是要被集中隔离或者居家隔离的。2021年1月28日春运开始 ,返乡人员需持7天内有效新冠病毒核酸检测阴性结果返乡,返乡后实行14天居家健康监测,期间不聚集 、不流动 ,每7天开展一次核酸检测。
揭阳来广州人员是否需要隔离,需根据其出发地风险等级及具体区域确定,具体如下:高风险地区来穗人员:实施“集中隔离14天” 。中风险地区来穗人员:实施“居家隔离14天 ”。惠来县旅居史来穗人员:实施3天居家健康监测+11天自我健康监测。
揭阳市属于广东省 。揭阳市 ,别称“榕城”,广东省辖地级市,地处粤港澳大湾区与海西经济区的地理轴线中心。全市陆地总面积 5240 平方千米 ,海域面积 930 平方千米。截至 2022 年 10 月,揭阳市辖榕城区、揭东区、揭西县 、惠来县、普宁市 2 区 2 县 1 市,市政府驻榕城区。
需要进行健康监测 。截至10月19日 ,揭阳现无中高风险区。点击查看根据珠海疫情防控政策:对揭阳市惠来县来珠人员,实施3天居家健康监测,期间不外出,第3天各开展一次核酸检测。对近7天有高风险区旅居史的来珠人员 ,采取7天集中隔离医学观察,在集中隔离第7天各开展一次核酸检测 。
明天从广州惠州回长沙是不需要隔离的,广州惠州属于低风险地区 ,只要您健康码和行程码均为绿码,近期没有到过中高风险地区就是可以的啊。
四川汕尾属于哪个市 汕尾市是一个市级城市,它的所属为省级 截至2019年 ,汕尾市属于广东省。汕尾市位于广东省东南部沿海,东临揭阳市,同惠来县交界;西连惠州市 ,与惠东县接壤;北接河源市,和紫金县相连;南濒南海 。昨天坐火车到新疆乌鲁木齐,就有疫情发生 ,我还能去伊犁吗 我是伊利奎屯这边的。
广东没有疫情的城市
中国唯一没有疫情的城市是广东省云浮市。这次新冠肺炎疫情几乎席卷了全国,就连圣洁的西藏都没幸免,然而如此险峻的环境下,却有一些城市依然保持着0确诊0感染 ,除了云端之上的云浮,还有东方湿地之城东营、长白仙境下的白山市、大清的龙兴之地抚顺 、边陲小城崇左,这些低调的小城市 ,已经成为一片无疫的净土 。
广东省云浮市。中国唯一没有疫情的城市是广东省云浮市。
自2020年新冠疫情在我国全面爆发以来,几乎所有的省市自治区都出现了疫情,但在疫情相对较严重的南方地区 ,广东省云浮市却是一个神奇的存在,它是全国唯一一个没有疫情的城市 。
本文来自作者[南城]投稿,不代表取之有道立场,如若转载,请注明出处:https://wap.aixuemima.com/quzhi/44649.html
评论列表(4条)
我是取之有道的签约作者“南城”!
希望本篇文章《揭阳市有没有新冠疫情/揭阳市是否有新型冠状病毒》能对你有所帮助!
本站[取之有道]内容主要涵盖:取之有道,生活百科,小常识,生活小窍门,百科大全,经验网,游戏攻略,新游上市,游戏信息,端游技巧,角色特征,游戏资讯,游戏测试,页游H5,手游攻略,游戏测试,大学志愿,娱乐资讯,新闻八卦,科技生活,校园墙报
本文概览:广东揭阳算不算疫情风险区?广东揭阳不算疫情风险区。截至2022年4月9日,揭阳均为低风险地区。揭阳居民出...